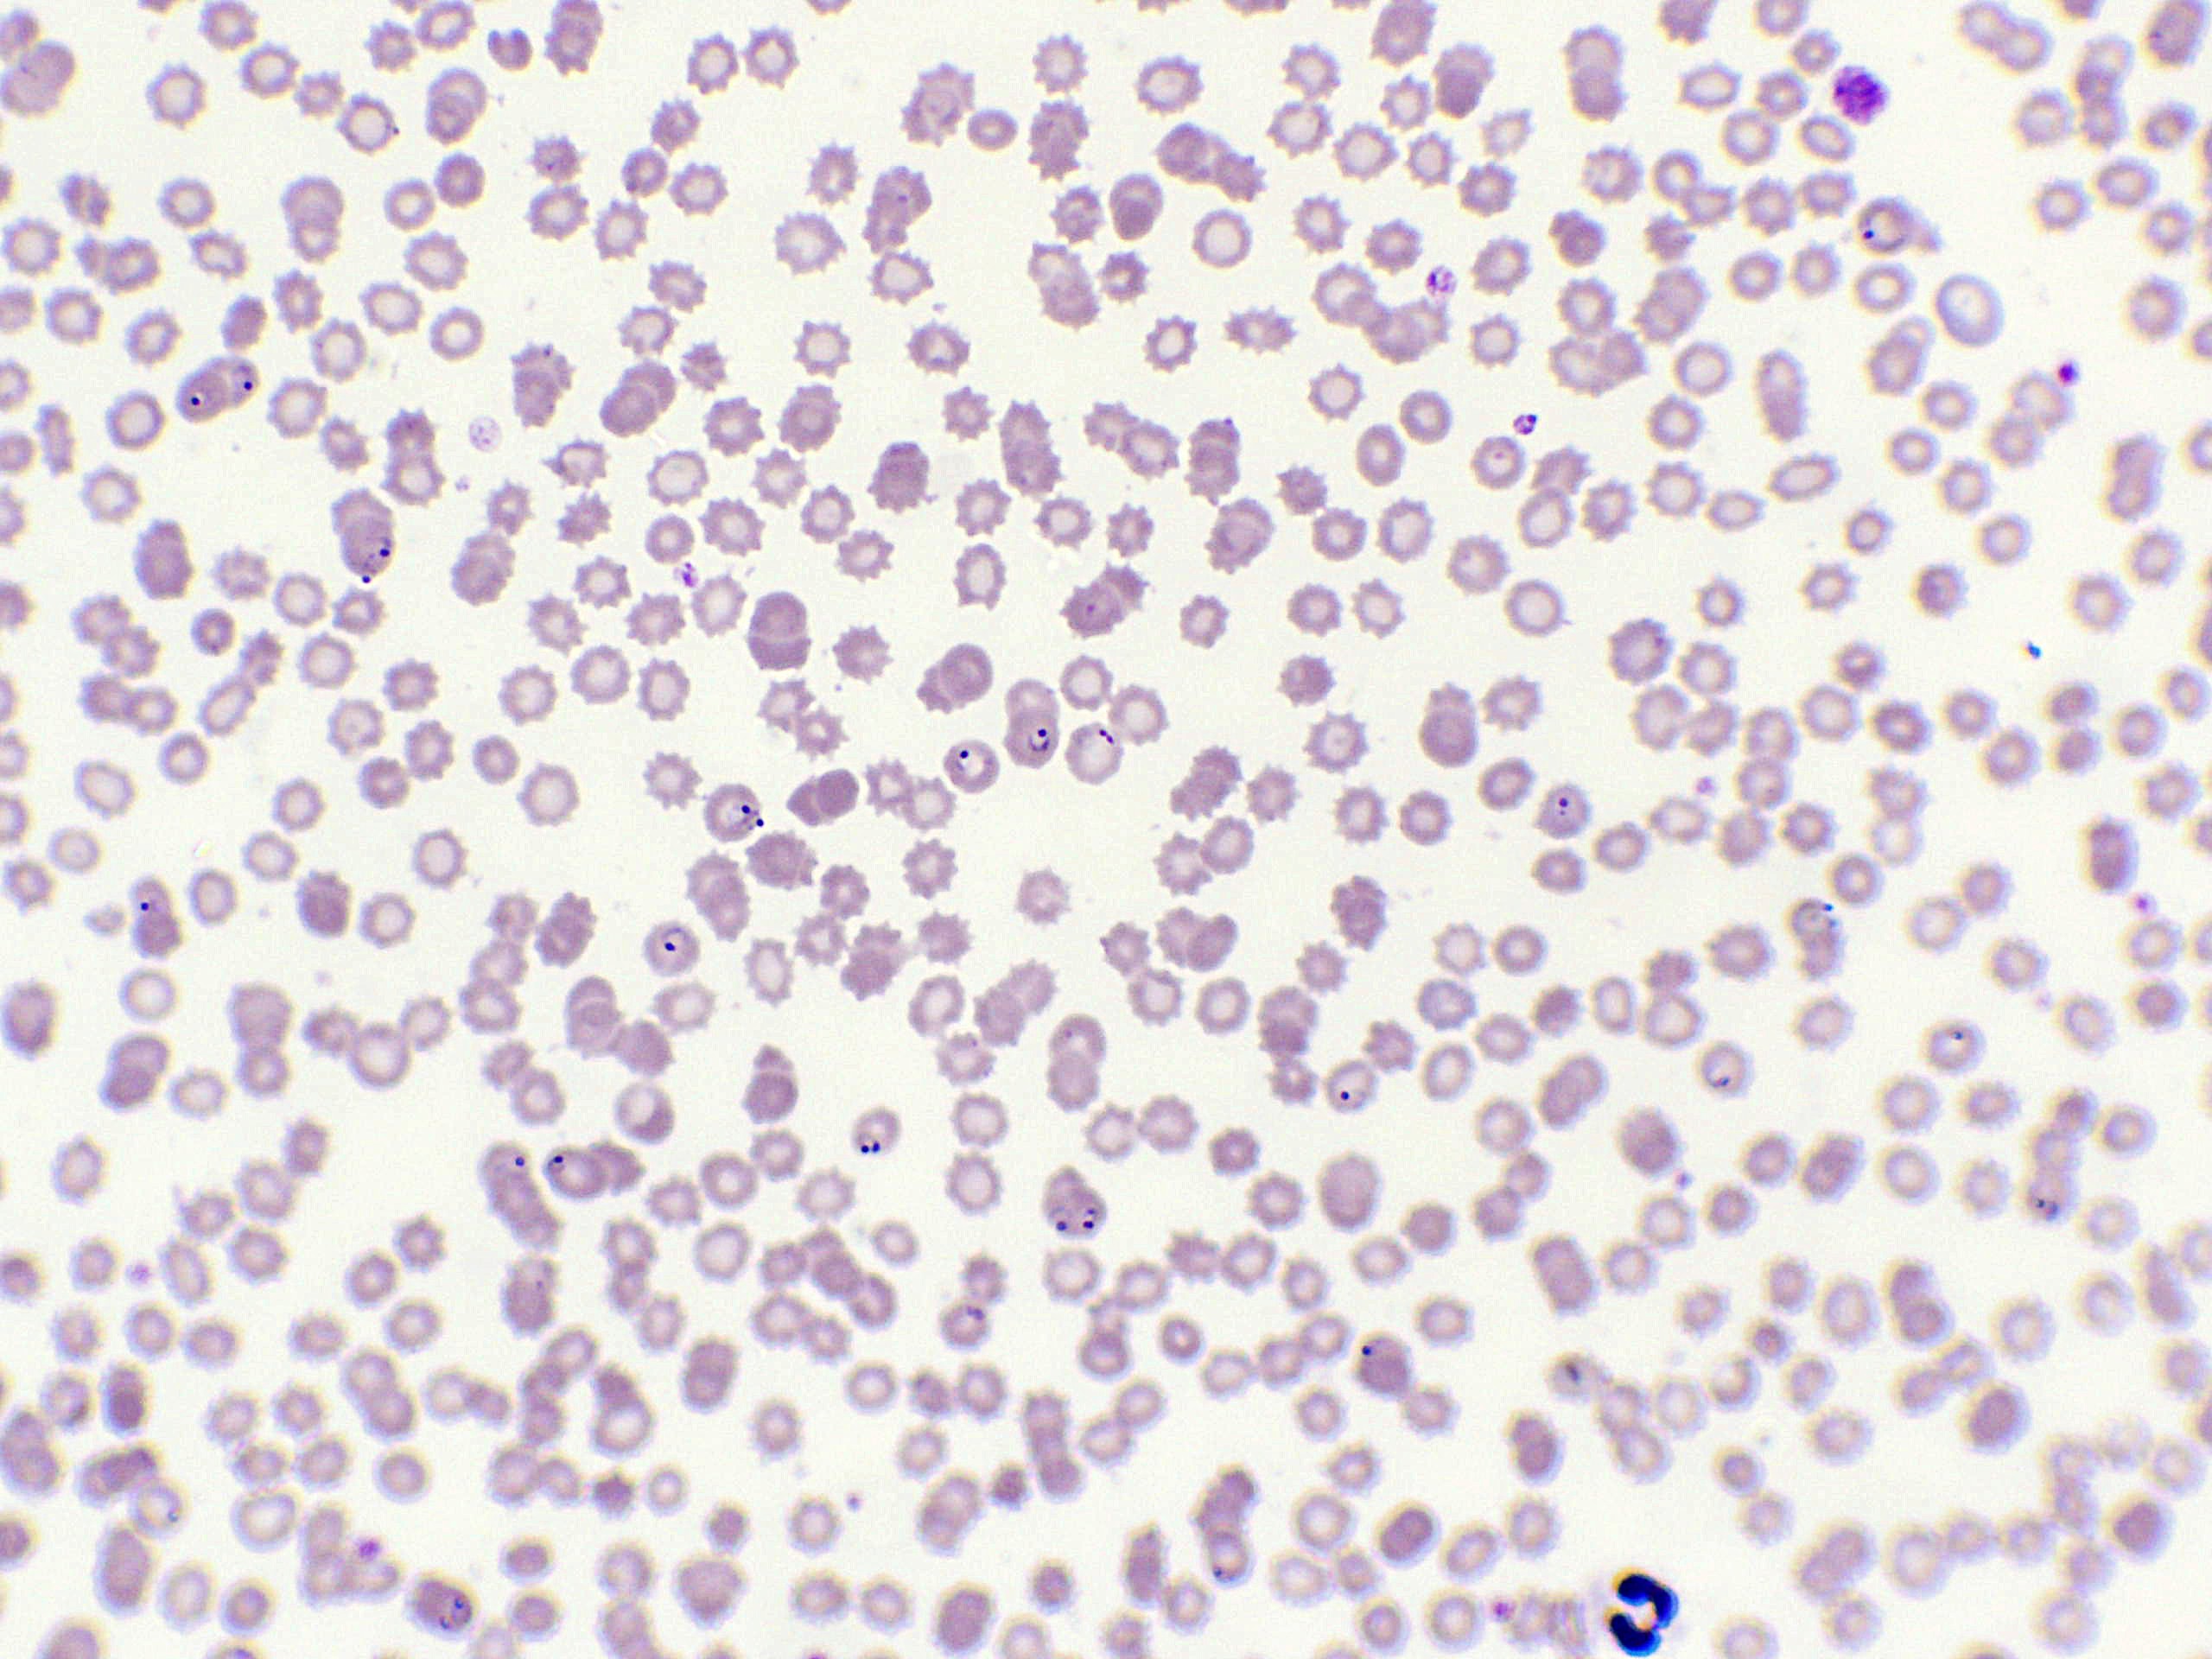

760F – Préparation microscopique sang plasmodium
individu atteint de paludisme
Notre sélection de produits biology
Ressources pédagogiques
Enrichissez vos cours de SVT avec des contenus prêts à l’emploi, conçus pour faciliter votre quotidien d’enseignant. Nous mettons à votre disposition une bibliothèque exclusive de fiches pédagogiques gratuites, élaborées en collaboration avec des professeurs de sciences expérimentés.
Accéder aux Ressources